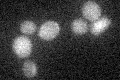
YIR037W
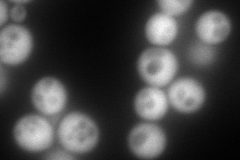
YIR037W
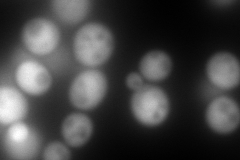
YIR037W
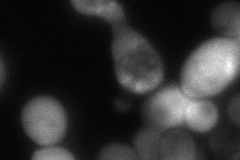
YIR037W
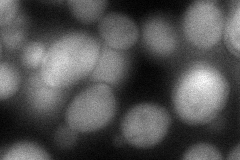
YIR037W
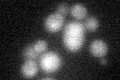
YIR037W

View description
Thiol peroxidase that functions as a hydroperoxide receptor to sense intracellular hydroperoxide levels and transduce a redox signal to the Yap1p transcription factor
Localization:
Intensity:
Fold change:
Significance:
-
C’ GFP library in SD
below threshold17.73 -
N' NOP1pr-GFP in SD
cytosol458.408 -
N' TEF2pr-mCherry in SD
cytosol713.782 -
N' NATIVEpr-GFP in SD
cytosol74.5323 -
N' TEF2pr-VC and Cyto-VN in SD
cytosol79.5682 -
C’ GFP library in SD+DTT
cytosol15.470.87No -
C’ GFP library in SD+H2O2

cytosol16.40.92No -
C’ GFP library in Starvation Media

cytosol16.160.91No -
C’ GFP library on the background of Pup2-DaMP

below threshold -
C’ GFP library on the background of CCT mutant

below threshold17.20940.970292No
